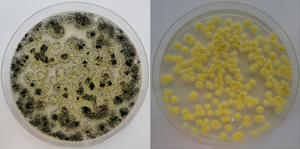

Comparison of original wild type Aspergillus niger colony and final mutant on agar plates.
Reprinted from Ref 1, Copyright 2015, with permission from Elsevier.
Filamentous fungi produce powerful enzymes that break down tough plant material that can be used for biofuels and other industrial processes. But the enzymes often work too slowly for industrial use and the fungi are difficult to handle in the lab. Now A*STAR scientists have altered a strain of the fungus, Aspergillus niger, to coax it into better shape.
Breaking down hemicellulose — complex carbohydrates in plant material — is a critical and tricky step in the production of industrial-purpose fermentable sugars. Filamentous fungi produce just the right mix of enzymes to do a complete job. The enzymes are also more powerful than those produced by other microorganisms such as bacteria or yeast commonly used in industrial microbial fermentation. But the fungus’ enzymes need a boost, says Jin Chuan Wu, lead researcher of the team from the A*STAR Institute of Chemical and Engineering Sciences.
“The structural complexity of hemicellulose means that to completely hydrolyse it requires the synergistic action of a cocktail of enzymes,” says Wu. “Therefore it is essential to improve the cocktail of enzymes produced by fungi.”
Wu and his colleagues exposed a strain of A. niger to γ-ray radiation to tweak its genetic material, hoping to increase the activity of the enzyme, β-1,4-endoxylanase produced by the fungus. The team grew the mutant fungus strains on agar plates (see image) and extracted, in pellet form, the enzyme from the resultant various fungal colonies and then tested the rate at which the enzyme works.
They selected the best performing fungus colonies and subjected them to another round of γ-ray radiation with exciting results. The most successful of the second round of mutants produced enzymes that hydrolyse at almost twice the rate as the originals. There were also other benefits: the mutant strain, called A. niger DSM 28712, also formed fewer and smaller pellets making it easier for researchers to handle as well as making it more suitable for industrial applications using submerged fermentation where the enzymes are put to use in a liquid substrate.
“This research shows that by simply using γ-ray radiation, the fungal strain could be significantly improved for both its cellular morphology and enzyme activity,” says Wu. “The improvements are favorable for industrial applications in hydrolysing hemicellulose to get fermentable sugars.”
Wu anticipates interest from industry in the enzymes once the price of sugars produced from plant material becomes more competitive.
The A*STAR-affiliated researchers contributing to this research are from the Institute of Chemical and Engineering Sciences.